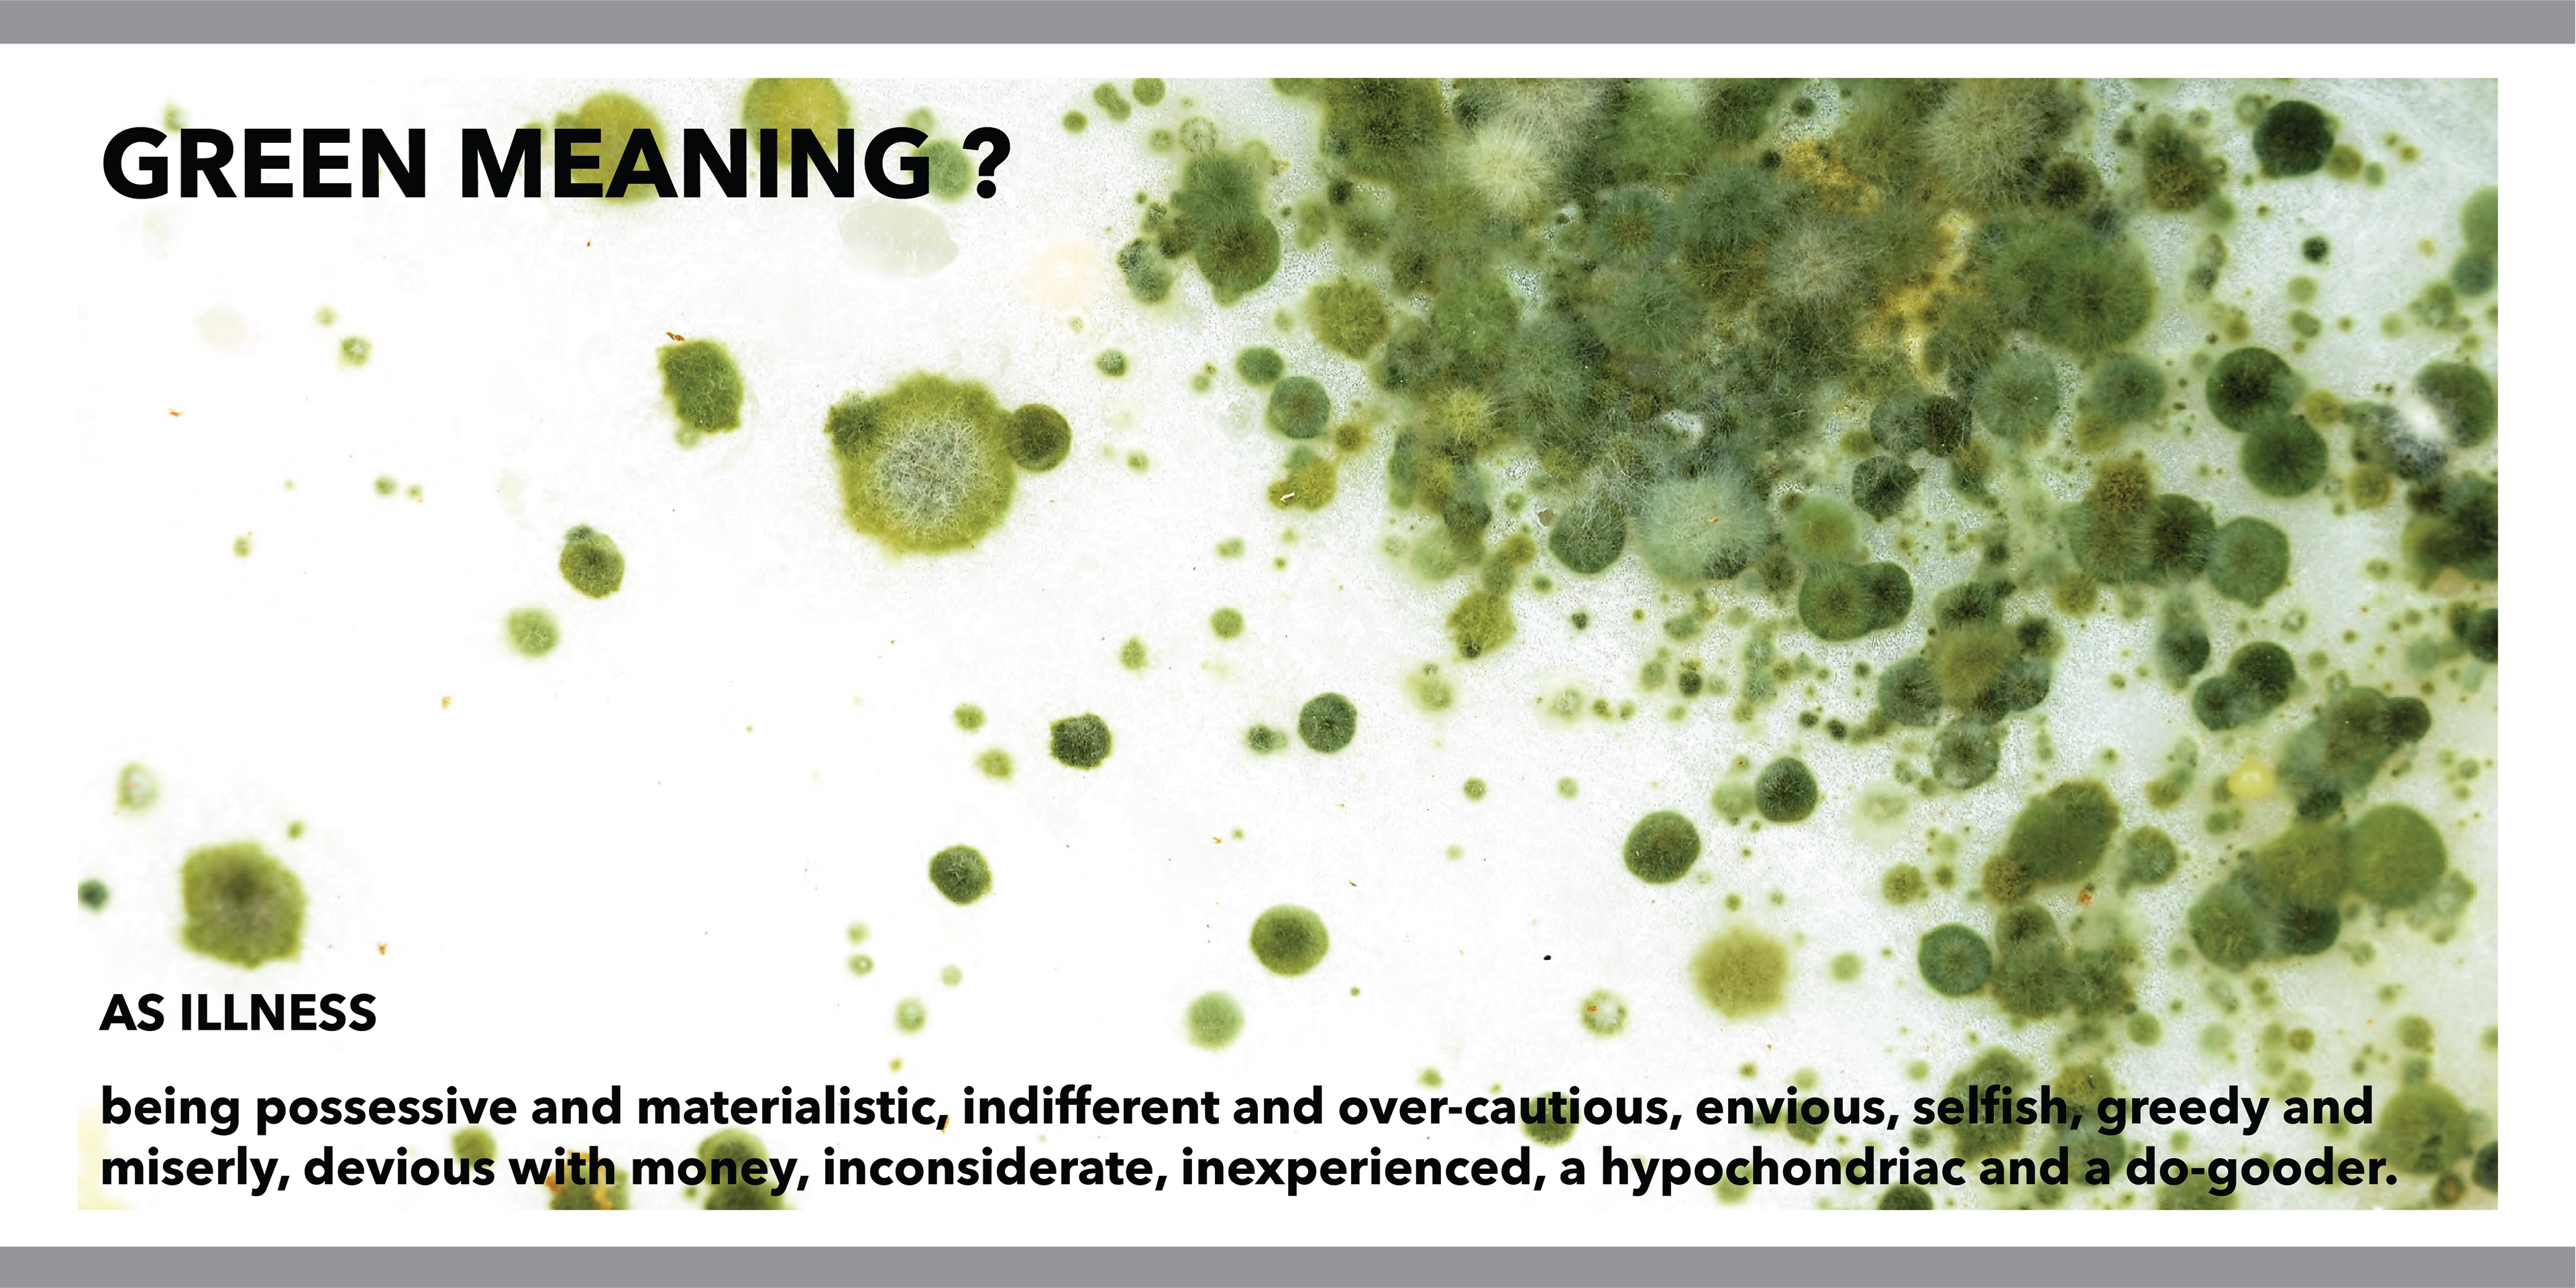

CMF
↓MATERIAL CONNEXION TOUR MANAGEMENT
Material ConneXion is a leading material science resource that connects brands with the world’s most innovative and sustainable materials. As a professor assistant, I was in charge of budgeting, communication, leadership, and follow-up management.

























↓ CMF LANGUAGES
















































































































↓ EXERCISE































































































↓ COLOR

↓ MATERIAL

















↓ FINISHING




























































3D DESIGN
Product Design
↓ SHOES STERILIZER

Display

Working Mock-up





























↓ peg lamp





↓ ROLLY POLLY STOOL














↓ safe aerosol to prevent wild cats from entering indoors
























↓ RECYCLING BEAN

↓ REMOTE CONTROL


↓ HAIR DRYER


3D Scan & modeling reverse
↓ Gun




















↓ PHOTO–SCAN





CAID

Clock

Clock

Table Clock

Clock

Container

Humidifier

TV

Flashlight

Pull toy

Snowman

Juicer

Squeezer

PS 2002

Kettle
Drawing


Mechanical Engineering


















